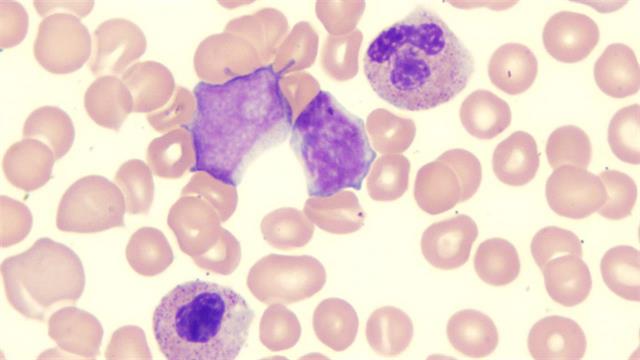
Η Novartis λαμβάνει από τον FDA χαρακτηρισμό διαδικασίας ταχείας αξιολόγησης για το sabatolimab

Η Novartis ανακοίνωσε ότι έλαβε από τον Οργανισμό Τροφίμων και Φαρμάκων των ΗΠΑ (FDA) τον χαρακτηρισμό διαδικασία ταχείας αξιολόγησης (fast track designation) του sabatolimab (MBG453) για τη θεραπεία ενηλίκων ασθενών με μυελοδυσπλαστικά σύνδρομα (MDS) υψηλού ή πολύ υψηλού κινδύνου κατά IPSS-R, σε συνδυασμό με υπομεθυλιωτικούς παράγοντες. Ο χαρακτηρισμός διαδικασίαςταχείας αξιολόγησης διευκολύνει την ανάπτυξη και επιταχύνει την αξιολόγηση των φαρμάκων για τη θεραπεία σοβαρών παθήσεων και την κάλυψη ανεκπλήρωτων ιατρικών αναγκών.
- Τα MDS, μια ομάδα σπάνιων και συχνά υποδιαγνωσμένων αιματολογικών καρκίνων, χαρακτηρίζονται από δυσλειτουργία του ανοσοποιητικού συστήματος και πολλαπλασιασμό λευχαιμικών βλαστών.
- Παρά τη θεραπεία με υπομεθυλιωτικούς παράγοντες (HMA) - την τελευταία θεραπευτική καινοτομία εδώ και 15 χρόνια για τα υψηλότερου κινδύνου MDS - οι ασθενείς επιδεικνύουν κακές εκβάσεις, όπως περιορισμένη διάρκεια ανταπόκρισης, ενώ ο διάμεσος χρόνος συνολικής επιβίωσής τους είναι κάτω από ένα έτος.
- Το sabatolimab είναι μια υπό έρευνα, πρώτη στην κατηγορία της, ανοσο-μυελική θεραπεία που συνδέεται με τον TIM- 3, ένα νέο στόχο που εκφράζεται σε πολλούς τύπους ανοσοκυττάρων και λευχαιμικών κυττάρων και βλαστών, αλλά όχι στα φυσιολογικά αρχέγονα κύτταρα που είναι υπεύθυνα για την αιμοποίηση. Είναι υπό ανάπτυξη για τα MDS υψηλού κινδύνου και την οξεία μυελογενή λευχαιμία(AML).
Το πρόγραμμα κλινικών δοκιμών STIMULUS περιλαμβάνει πολλές μελέτες αξιολόγησης του sabatolimab ως μέρους διαφορετικών θεραπευτικών συνδυασμών σε ασθενείς με MDS και AML, συμπεριλαμβανομένων των μελετών STIMULUS-MDS1 Φάσης ΙΙ STIMULUS-MDS2 Φάσης III STIMULUS-MDS3 Φάσης ΙΙ STIMULUS-AML1 Φάσης ΙΙ.
Προσθέστε το iatronet.gr στο DiscoverΕιδήσεις υγείας σήμερα
Μητσοτάκης από τη Ρόδο: Νέο νοσοκομείο €45 εκατ. στην Κω
Τροφές που μπορεί να προκαλέσουν ημικρανία
Ν.Δημάσης: Γιατί πρέπει να μπει στο ''Προλαμβάνω'' ο καρκίνος του προστάτη
Χάπι για τη λευχαιμία πιθανόν βοηθά και στο μυελοδυσπλαστικό σύνδρομο
Χάπι για τη λευχαιμία πιθανόν βοηθά και στο μυελοδυσπλαστικό σύνδρομο Επιστημονική Ημερίδα για τα κακοήθη αιματολογικά νοσήματα
Επιστημονική Ημερίδα για τα κακοήθη αιματολογικά νοσήματα Νέες θεραπευτικές επιλογές σε ασθενείς με μυελοδυσπλαστικά σύνδρομα
Νέες θεραπευτικές επιλογές σε ασθενείς με μυελοδυσπλαστικά σύνδρομα  Μυελοδυσπλαστικά σύνδρομα
Μυελοδυσπλαστικά σύνδρομα Ν.Δημάσης: Γιατί πρέπει να μπει στο ''Προλαμβάνω'' ο καρκίνος του προστάτη
Ν.Δημάσης: Γιατί πρέπει να μπει στο ''Προλαμβάνω'' ο καρκίνος του προστάτη Τι συνέβη όταν 12 άνθρωποι συμβίωναν στην Ανταρκτική για 10 μήνες
Τι συνέβη όταν 12 άνθρωποι συμβίωναν στην Ανταρκτική για 10 μήνες Τροφές που μπορεί να προκαλέσουν ημικρανία
Τροφές που μπορεί να προκαλέσουν ημικρανία Μητσοτάκης από τη Ρόδο: Νέο νοσοκομείο €45 εκατ. στην Κω
Μητσοτάκης από τη Ρόδο: Νέο νοσοκομείο €45 εκατ. στην Κω Πώς να χαλαρώσετε το βράδυ χωρίς αλκοόλ
Πώς να χαλαρώσετε το βράδυ χωρίς αλκοόλ Εγκαίνια 2 νέων αξονικών τομογράφων και της νέας Καρδιολογικής Κλινικής στο Γενικό Ογκολογικό Νοσοκομείο Κηφισιάς ''Οι Άγιοι Ανάργυροι''
Εγκαίνια 2 νέων αξονικών τομογράφων και της νέας Καρδιολογικής Κλινικής στο Γενικό Ογκολογικό Νοσοκομείο Κηφισιάς ''Οι Άγιοι Ανάργυροι'' 9 εξακριβωμένα οφέλη του κολοκυθόσπορου
9 εξακριβωμένα οφέλη του κολοκυθόσπορου Θεσσαλονίκη: Αγώνας ζωής για ένα μικρό θαύμα 470 γραμμαρίων
Θεσσαλονίκη: Αγώνας ζωής για ένα μικρό θαύμα 470 γραμμαρίων Χαλκιδική: Ο Μάρτιν βγήκε από τη ΜΕΘ και βρήκε τον γιατρό που τού έσωσε τη ζωή
Χαλκιδική: Ο Μάρτιν βγήκε από τη ΜΕΘ και βρήκε τον γιατρό που τού έσωσε τη ζωή ΔΕΠΥ: Πώς εμφανίζεται στις γυναίκες και γιατί συχνά αργεί η αναγνώριση
ΔΕΠΥ: Πώς εμφανίζεται στις γυναίκες και γιατί συχνά αργεί η αναγνώριση Καρπούζι: Ποια είναι τα οφέλη του στην υγεία
Καρπούζι: Ποια είναι τα οφέλη του στην υγεία CDC: Ανησυχία για ανεξέλεγκτη εξάπλωση του Έμπολα
CDC: Ανησυχία για ανεξέλεγκτη εξάπλωση του Έμπολα Η Μαριάντζελα Οικονομοπούλου αναλαμβάνει τη θέση της SEE Head of Access & External Engagement στην UCB
Η Μαριάντζελα Οικονομοπούλου αναλαμβάνει τη θέση της SEE Head of Access & External Engagement στην UCB